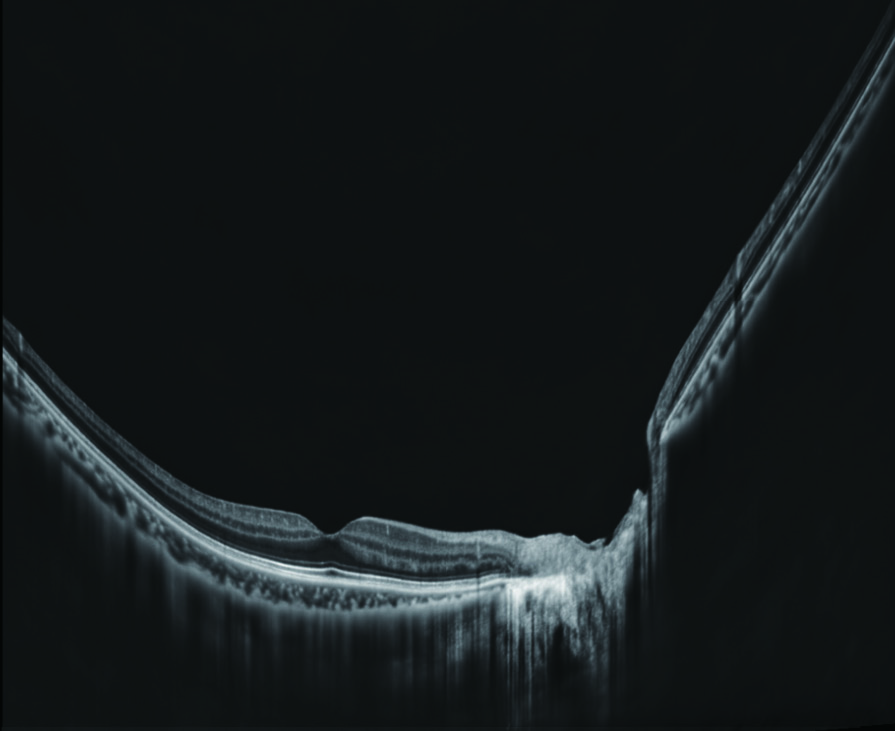

Nidek RS-1 Glauvas SLO/OCT
RS‑1 Glauvas er et moderne OCT‑system utviklet for grundig vurdering og oppfølging av glaukom og andre øyesykdommer. Løsningen kombinerer høy teknisk ytelse med praktisk brukervennlighet, og er godt egnet for klinikker med behov for raske, pålitelige undersøkelser.
Viktige egenskaper
- Høy skannehastighet: Opptil 250 kHz gir skarpe OCT‑bilder på kort tid og bidrar til effektiv pasientflyt.
- Stor dybde og bred dekning: I ett enkelt B‑skann kan området fra papille til den temporale kararkaden fremstilles. Med en skannedybde på opptil 4,2 mm kan større deler av netthinnen inkluderes, noe som gir en presis gjengivelse også hos myope øyne.
- Høyoppløselig OCT‑angiografi: Detaljert visualisering av mikrovaskulatur med forbedret kontrast takket være CODAA2‑algoritmen. Den brede og presise angiografien muliggjør effektiv, ikke‑invasiv vurdering av karsykdommer i netthinnen og kan redusere behovet for kontrastbaserte undersøkelser.
- Avansert analyse: RS‑1 Glauvas benytter deep learning‑baserte analysealgoritmer for presis vurdering av strukturelle og vaskulære endringer. Funnene presenteres lagvis i et Structural Normality Map, noe som kan bidra til å avdekke svært små avvik og som muliggjør tidlig identifisering av sykdomstegn.
- Enkel i bruk: Intuitivt grensesnitt og ergonomisk design for effektiv bruk i en klinisk hverdag.
RS‑1 Glauvas er utviklet for klinikere som ønsker høy presisjon og en smidig arbeidsflyt.
- Klikk her for brosjyre
- Klikk her for å se RS-1 på Nidek sin hjemmeside
- Klikk her for å besøke Nidek sitt videogalleri
- Artikkel: Advanced Retinal Imaging in High-Volume Clinics: Advantages of OCT-A on the RS-1 Glauvas in daily practice.

Macula line 16.5 mm - Scan depth 4.2 mm / OCT-Angiography 6 x 6, 9 x 9, 12 x 12 mm

Retina Map 15 x 12 mm

OCT-Angiography 12 x 12 mm

Instrumentbord Block Exclusiv
- Alt i ett løsning, plass for OCT, PC, Monitor og mus/tastatur
- Svært god pasientkomfort, egner seg for rullestoler
- Kan leveres speilvendt
- Tysk kvalitet
- Variant med plass til 2 eller 3 instrumenter tilgjengelig
- Avbildet OCT er Nidek RS-330 Duo
- RS-1 kan også leveres med instrumentbord / rack løsning
- Klikk her for mer info!

